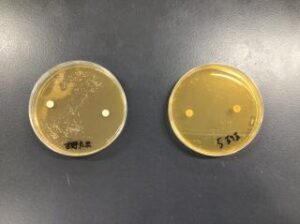

わんにゃん通信No.2115「2年生授業参観」
 毎日飼育当番でボディーチェックを行っているため、チェックポイントをしっかり把握していますね!
毎日飼育当番でボディーチェックを行っているため、チェックポイントをしっかり把握していますね!

 異常がないことを確認して、予防薬の投与を行いました。
次に薬剤感受性試験の評価を実施しました。
薬剤感受性試験は、細菌や真菌に対する抗菌薬の効果を評価するための手法です。
寒天培地にできる阻止円径を測定し、どの薬剤がどのくらい効果があるのかを判定する方法になっています。
異常がないことを確認して、予防薬の投与を行いました。
次に薬剤感受性試験の評価を実施しました。
薬剤感受性試験は、細菌や真菌に対する抗菌薬の効果を評価するための手法です。
寒天培地にできる阻止円径を測定し、どの薬剤がどのくらい効果があるのかを判定する方法になっています。
 阻止円の直径を測定しています。
阻止円の直径を測定しています。
どんな結果になったでしょうか。
短い時間でしたが、楽しい授業参観になったと思います。
引き続き、楽しく真剣に頑張っていきましょう!
日頃の授業の様子を見て貰えて良かったです!
どんな結果になったでしょうか。
短い時間でしたが、楽しい授業参観になったと思います。
引き続き、楽しく真剣に頑張っていきましょう!
日頃の授業の様子を見て貰えて良かったです!
 人気ブログランキング
人気ブログランキング
















